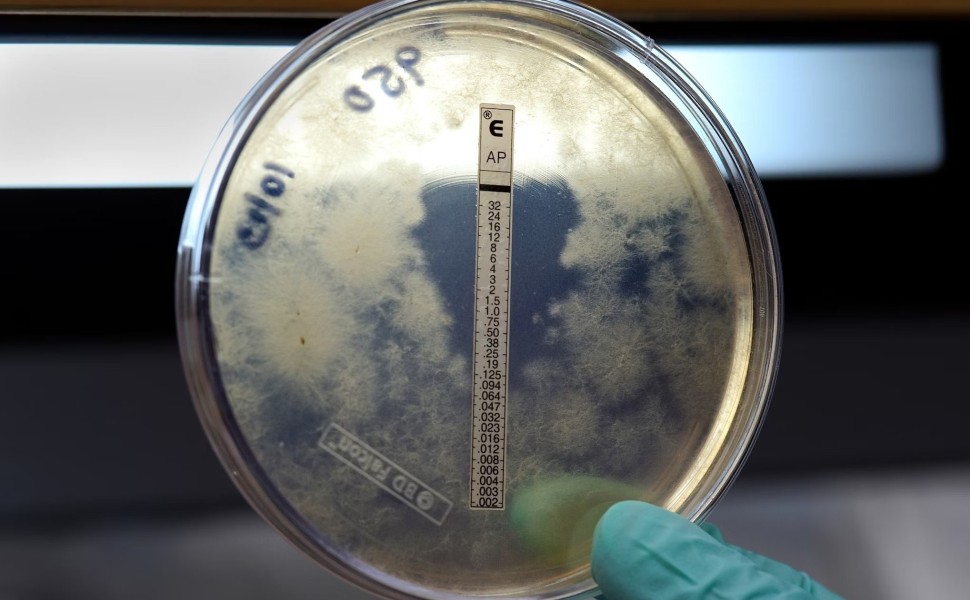

Τι είναι η κεραυνοβόλος μηνιγγίτιδα: Τα συμπτώματα και η πρόληψη
Η θνησιμότητα για όσους προσβάλλονται από κεραυνοβόλο μηνιγγίτιδα κυμαίνεται μεταξύ 8 και 13%.
Η οξεία μηνιγγιτιδοκοκκαιμία και η κεραυνοβόλος μηνιγγιτοδοκοκκαιμία με ή χωρίς μηνιγγίτιδα είναι μία από τις λιγοστές λοιμώξεις που είναι ικανές να «σκοτώσουν», εντός ωρών ένα προηγουμένως υγιές άτομο. Ένα 25% των λοιμώξεων από μηνιγγιτιδόκοκκο εκδηλώνεται αρχικά ως οξεία μηνιγγιτιδοκοκκαιμία και ένα 50% των μηνιγγίτιδων συνοδεύεται από σημεία μηνιγγιτιδοκοκκαιμίας. Συχνά τα αρχικά συμπτώματα είναι μη ειδικά και η διάγνωση καθυστερεί.
Η επίπτωση των μηνιγγιτιδοκοκκικών λοιμώξεων κυμαίνεται μεταξύ 0,1 έως 1,5 περιστατικά σε γενικό πληθυσμό 100.000 ατόμων και δεν έχει αλλάξει τα τελευταία 40 χρόνια. Προσβάλλει κυρίως παιδιά και νεαρής ηλικίας άτομα. Υπάρχει εποχιακή κατανομή και τα περισσότερα περιστατικά εμφανίζονται χειμώνα και άνοιξη. Ο επιπολασμός των ασυμπτωματικών φορέων ποικίλλει από 2% στα παιδιά ηλικίας μικρότερης των 2 ετών, έως 10-40% μεταξύ των εφήβων και νεαρών ενηλίκων, ιδιαίτερα στρατιωτών και φοιτητών.
Σύμφωνα με τους SOS ΙΑΤΡΟΙ, η θνησιμότητα ποικίλλει μεταξύ 8 και 13%. Οι επιζήσαντες μιας μηνιγγιτιδοκοκκικής λοίμωξης εμφανίζουν σε ποσοστό που αγγίζει το 20% επιπλοκές όπως κώφωση, νευρολογικά ελλείμματα, ακρωτηριασμούς. Ο αιτιολογικός παράγοντας της μηνιγγίτιδας είναι ο Gram αρνητικός διπλόκοκκος Neisseria meningitidis, του οποίου μόνος ξενιστής είναι ο ρινοφάρυγγας των ανθρώπων.
Τα συμπτώματα
Η οξεία μηνιγγιτιδικοκκαιμία χαρακτηρίζεται από την αιφνίδια έναρξη, την ταχεία εξέλιξη και την απουσία φλεγμονώδους εστίας λοίμωξης. Η εισβολή έχει βαρύτερη εικόνα και από εκείνη της μηνιγγίτιδας: υψηλός πυρετός, ρίγη και μυαλγίες κυρίως των άκρων και της οσφύος, όπως και έμετοι ή διάρροιες. Ασθενείς με τα ανωτέρω συμπτώματα και πριν την εμφάνιση του εξανθήματος κατά την επίσκεψη του γιατρού στο σπίτι ή στα τμήματα των επειγόντων είναι πιθανώς να μην εκτιμηθούν σωστά και να θεωρηθούν λανθασμένα ιογενείς λοιμώξεις.
Προοδευτικά, εντός ωρών όλοι οι ασθενείς με οξεία μηνιγγιτιδοκοκκαιμία εμφανίζουν εξάνθημα που αρχικά μπορεί να είναι πετεχειώδες, κηλιδοβλατιδώδες ή αιμορραγικό. Προοδευτικά, όμως, εντός ωρών πάντα εξελίσσεται σε αιμορραγικό και συνήθως συρρέει για να σχηματίσει ευμεγέθεις πορφυρικές (αιμορραγικές) βλάβες. Αντίθετα, στις ιογενείς λοιμώξεις το εξάνθημα εμφανίζεται αρκετές μέρες μετά την εμφάνιση του πυρετού.
Ο δωρεάν εμβολιασμός
Ο καλύτερος τρόπος να προληφθεί η μηνιγγιτιδοκοκκική μηνιγγίτιδα είναι ο εμβολιασμός. Μέχρι πρότινος το εμβόλιο για τη μηνιγγίτιδα Β δεν καλυπτόταν στη χώρα μας. Αυτό έχει ως αποτέλεσμα τα περισσότερα παιδιά και νεαροί ενήλικες να είναι ανεμβολίαστοι.
Τα επιδημιολογικά δεδομένα που δείχνουν ότι η μεγαλύτερη επίπτωση διεισδυτικής μηνιγγιτιδοκοκκικής νόσου είναι σε βρέφη σε συνδυασμό με την επαναφορά των κρουσμάτων σε προπανδημικά επίπεδα – ακόμη χαμηλά βέβαια – ήταν ανάμεσα στους λόγους που οδήγησαν πριν πέντε μήνες την Εθνική Επιτροπή Εμβολιασμών να εντάξει το εμβόλιο κατά της μηνιγγίτιδας Β στο Εθνικό Πρόγραμμα Εμβολιασμών για βρέφη κάτω του ενός έτους. Η ανάγκη ανοσοποίησης κλειστών πληθυσμών, όπως είναι οι φοιτητές σε εστίες, απασχολεί τους επιστήμονες μέλη της Εθνικής Επιτροπής Εμβολιασμών.
Σύμφωνα με τις επίσημες οδηγίες, ο εμβολιασμός πρέπει να διενεργείται με έναρξη από την ηλικία των δυο μηνών και χορήγηση 3 δόσεων με σχήμα 2+1 στις ηλικίες 2, 4 και 12 μηνών αντίστοιχα. Επισημαίνεται, ότι η έγκαιρη έναρξη έχει μεγάλη σημασία διότι η μέγιστη επίπτωση της νόσου στην Ελλάδα καταγράφεται στη βρεφική ηλικία και μάλιστα κατά τους πρώτους έξι μήνες της ζωής.
Αξίζει να σημειωθεί ότι για όσες ηλικίες δεν αποζημιώνεται, το εμβόλιο κοστίζει περίπου 100 ευρώ η δόση και απαιτούνται τρεις δόσεις. Εάν μια οικογένεια έχει δύο και τρία παιδιά, είναι εύκολα κατανοητό ότι πρόκειται για ένα πολύ σημαντικό ποσό που πρέπει να δώσει, για αυτό και οι περισσότερες οικογένειες δεν το έχουν κάνει παρότι οι παιδίατροι το συστήνουν. Ενδεικτικά, τα τελευταία δύο χρόνια έγιναν περίπου 333.000 εμβόλια για τη μηνιγγίτιδα Β σε παιδιά και εφήβους, με τις οικογένειες να πληρώνουν περίπου 27 εκατ. ευρώ για την αγορά τους.
Δείτε όσα είπε στο Action 24 ο πρόεδρος του ΕΟΔΥ, Χρήστος Χατζηχριστοδούλου: